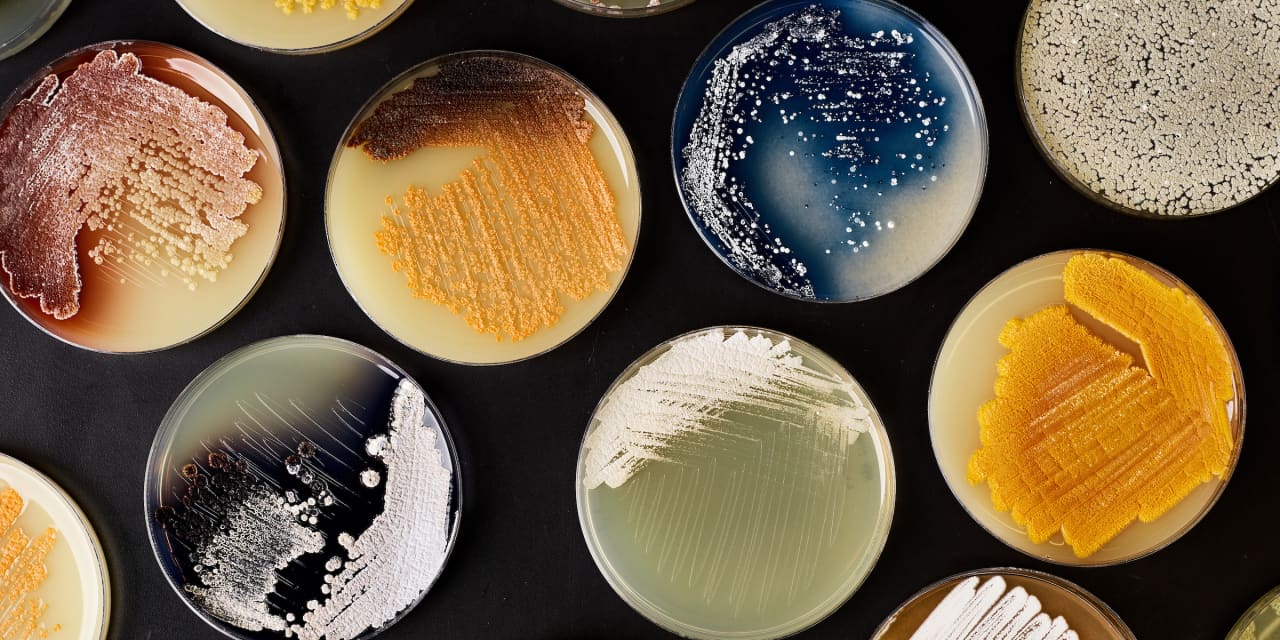
ProjectOption's tweet card. Wall Street is catching on to the huge promise of firms that can use the raw materials of life to create useful products.

ProjectFinance
@ProjectOption
https://youtu.be/sCBL49v1SJs
قد يعجبك
Back to work ! Will be posting Multiyear breakout stocks today. Stay tuned. Show some love. Like and Retweet for better reach.
Thread from my prep for tonight's podcast on Amyris $AMRS. What is synthetic biology?

Tastytrade Mechanics on 2 Sheets. 🍒 @tastytrade @thetastyworks @small_exchange @luckboxmag @Tony_BATtista @mrechenthin @AntonKulikov97 @JuliaSpina5 @kai_zeng1 @mikehart79 @jschultzf3 @ProjectOption youtu.be/TiE8r-f23rs
youtu.be/sCBL49v1SJs enjoy! Let me know what you think and like and subscribe if you haven’t yet. Thanks guy. 🙏
A lot of money pumping into the market today. #Bulls on parade? #StockMarket #OptionsTrading
What price are you guys eyeing to load up more Bitcoin? Will it get back to 60k or sub 40k first? Thoughts?
$Amrs yahoo.com/lifestyle/excl… Could be a great long play, something to keep an eye on. $Amrs
The boat is floated, that has to be good news before open.
This and if you need help come join me on YouTube.
If you bought a Tesla Model S in 2012, your $77,000 car would be worth approximately $40,000 today. If you had invested that same $77,000 in Tesla stock, you would have over $7 million today. Invest your money instead of buying material things.
Possible Starship flight tomorrow afternoon
United States الاتجاهات
- 1. $TCT 1,474 posts
- 2. Cyber Monday 28.3K posts
- 3. Good Monday 33.3K posts
- 4. #MondayMotivation 6,560 posts
- 5. #MondayVibes 2,809 posts
- 6. TOP CALL 10.6K posts
- 7. #NavidadConMaduro 1,103 posts
- 8. Victory Monday N/A
- 9. Happy New Month 292K posts
- 10. #MondayMood 1,161 posts
- 11. Clarie 2,311 posts
- 12. #December1st 2,455 posts
- 13. Happy 1st 23.1K posts
- 14. John Denver 1,486 posts
- 15. Jillian 1,888 posts
- 16. Rosa Parks 2,591 posts
- 17. Bienvenido Diciembre 2,917 posts
- 18. Luigi Mangione 2,175 posts
- 19. Michael Saylor 6,225 posts
- 20. Honduras 202K posts
قد يعجبك
-
 Hardman & Co
Hardman & Co
@HardmanandCo -
 Sat
Sat
@SymbolSatoshi -
 Alex Salamanca
Alex Salamanca
@Alex2Salamanca -
 STOCK HunTeR
STOCK HunTeR
@ARNRAY777 -
 Ercilia
Ercilia
@Ercilia_113 -
 JeffreyR
JeffreyR
@_jeffreyr -
 Shital Ashar
Shital Ashar
@shital_ashar -
 Jerry
Jerry
@geraldmestas -
 Victoria Manley
Victoria Manley
@VictoriaManley7 -
 EnlightenedBitcoin - Running knots
EnlightenedBitcoin - Running knots
@AltcoinScanner -
 S͜͡u͜͡P͜͡e͜͡R͜͡ M͜͡o͜͡O͜͡n͜͡
S͜͡u͜͡P͜͡e͜͡R͜͡ M͜͡o͜͡O͜͡n͜͡
@luckylipservice -
 AJS Investing
AJS Investing
@ajsinvesting -
 Dan Carman
Dan Carman
@dan_carman -
 Jon Koctostan
Jon Koctostan
@memoisbill
Something went wrong.
Something went wrong.